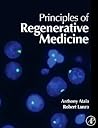
Principles of Reg...

Gaurav Chauhan
http://beneaththecymbalrush.blogspot.in/
“He did not want to play. He wanted to meet in the real world the unsubstantial image which his soul so constantly beheld. He did not know where to seek it or how, but a premonition which led him on told him that this image would, without any overt act of his, encounter him. They would meet quietly as if they had known each other and had made their tryst, perhaps at one of the gates or in some more secret place. They would be alone, surrounded by darkness and silence: and in that moment of supreme tenderness he would be transfigured.
He would fade into something impalpable under her eyes and then in a moment he would be transfigured. Weakness and timidity and inexperience would fall from him in that magic moment.”
― A Portrait of the Artist as a Young Man
He would fade into something impalpable under her eyes and then in a moment he would be transfigured. Weakness and timidity and inexperience would fall from him in that magic moment.”
― A Portrait of the Artist as a Young Man
“I have plenty of nothing; nothing is plenty for me; got my song; got heaven the whole day long.”
―
―
Gaurav’s 2024 Year in Books
Take a look at Gaurav’s Year in Books, including some fun facts about their reading.
More friends…
Polls voted on by Gaurav
Lists liked by Gaurav